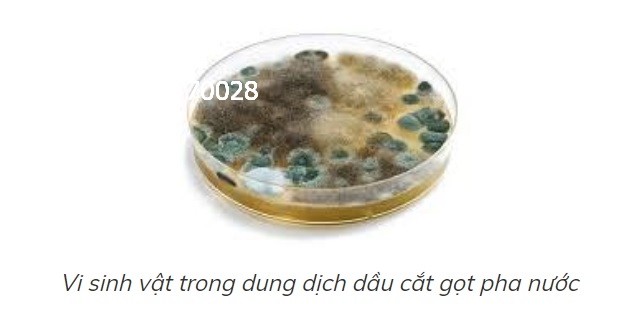
su-co-dau-cat-got-kim-loai-pha-nuoc

|
Từ khóa
Danh mục |
|
Đang truy cập: 250 Trong ngày: 685 Trong tuần: 941 Lượt truy cập: 9806726 |

Dầu cắt gọt kim loại gốc nước hay còn gọi là dầu tưới nguội, dầu cắt gọt pha nước, dầu mài… là giải pháp hàng đầu giúp bôi trơn, làm bóng lưỡi cắt và làm đẹp bề mặt vật liệu gia công trong ngành cơ khí. Tuy nhiên, việc sử dụng dầu cắt gọt kim loại gốc nước lại là vấn đề khiến người dùng lúng túng, bởi dầu dễ bị vi khuẩn tấn công, dễ bị tạo bọt, dễ bị gỉ sét trên thiết bị và thường có mùi khó chịu. . Để tránh những vấn đề này, dầu cắt gọt gốc nước phải được bảo dưỡng và chăm sóc đúng cách. Chúng tôi xin trình bày trường hợp của dầu phương pháp kiểm tra, xử lý trong từng trường hợp cụ thể.
6 Sự Cố Thường Gặp Với Dầu Cắt Gốc Nước Và Cách Khắc Phục
1. Dầu cắt gọt pha nước bị tắc nghẽn và phân hủy do sự phát triển của vi sinh vật
Mùi hôi từ dầu cắt gọt kim loại gốc nước là một vấn đề phổ biến khi sử dụng dầu cắt gọt kim loại gốc nước. Dầu cắt gọt bị phân hủy làm mất đi hầu hết các chức năng của dầu cắt gọt như làm mát, bôi trơn máy cắt, chống ăn mòn, rỉ sét cho hệ thống máy móc gây hại cho sức khỏe và môi trường làm việc do dầu cắt gọt bị phân hủy xử lý. Cần xả hết dầu củ và pha vào dầu cắt gọt mới với nồng độ do nhà sản xuất dầu khuyến cáo.
1.1 Cách tra dầu cắt gọt pha nước để tránh tình trạng này
+ Kiểm tra độ pH của dầu: Khoảng pH thông thường của dầu cắt gọt pha nước trung hòa nằm trong khoảng (8.6-10.6) là an toàn. Dầu cắt gọt bị phân hủy có xu hướng làm giảm độ pH của xuống.
+ Kiểm tra độ đậm đặc: Độ đặc là lượng dầu được trộn với nước để tạo thành dung dịch làm việc. Nồng độ thông thường của dầu cắt gọt kim loại nằm trong khoảng (5-10%). Tùy thuộc vào nồng độ sẽ được dung dịch bị phân hủy.
+ Kiểm soát sinh trưởng vi sinh: Sử dụng thiết bị kiểm tra vi sinh có thiết bị kiểm soát vi sinh vật BF, dễ dàng quan sát lượng nấm và sinh vật sinh trưởng.
Nếu trong trường hợp dung dịch chưa phân hủy hết có thể pha thêm dầu cắt gọt kim loại để tăng nồng độ và pH thích hợp và thêm chế phẩm diệt khuẩn diệt khuẩn vào máy làm lạnh đang hoạt động bình thường. Trong trường hợp dung dịch dầu cắt gọt kim loại gốc nước bị phân hủy quá nhiều, cần làm sạch thùng dầu cắt gọt và pha lại dầu mới.
2. Dầu cắt gọt kim loại gốc nước có bọt

Khi dầu cắt được trộn với nước khử ion, có xu hướng tạo bọt hoặc dầu cắt được phun ở tốc độ cao. Cần chọn loại dầu cắt gọt tạo ít bọt khi pha với nước khử ion, nếu Chất chống tạo bọt có thể được thêm vào theo yêu cầu của nhà cung cấp. Nếu để trạng thái sủi bọt lâu sẽ làm hiệu suất giảm, dung dịch dễ bay hơi. Dầu cắt gọt kim loại tạo bọt gốc nước
3. Dầu cắt gọt pha nước đổi màu kim loại màu

Trong các dung dịch gia công kim loại thường có phụ gia EP chống cực áp giúp xử lý các kim loại cứng khó gia công. Việc sử dụng phụ gia này không đúng cách sẽ làm thay đổi m màu như đồng, nhôm... sau khi gia công. Cần thay loại dầu cắt gọt phù hợp (có thể chọn dầu cắt gọt kim loại gốc nước Korea SHL không làm mất màu kim loại).
4. Dầu cắt gọt kim loại gốc nước nhanh phai màu

Dung dịch nước của dầu cắt gọt có xu hướng giảm nồng độ trong quá trình gia công, cần bổ sung một lượng dầu thích hợp sau mỗi ngày gia công. Sau đó nên trộn dầu cắt gọt với nước bể làm lạnh để đạt nồng độ từ 5 đến 10%. Kiểm tra bằng máy đo nồng độ Refectometer. Kiểm tra dung dịch dầu cắt gọt bằng Máy đo nồng độ Refectometer
5. Dung dịch dầu cắt gọt được tách ra

Khi dầu cắt gọt kim loại bị pha với nước cứng chứa nhiều ion Ca 2+ thì dung dịch dầu cắt gọt Mg 2+ có xu hướng tách ra, tạo nhiều váng dầu ở bề mặt và do dầu thủy lực, dầu mỡ lẫn vào nhau. chảy vào két làm mát. Điều này làm cho dầu cắt gọt dễ bị vi khuẩn tấn công hơn. Váng dầu nên được làm sạch thường xuyên.
6. Dầu cắt gọt pha nước lọc không sạch do gia công mài
Trong quá trình mài kim loại, dầu cắt được trộn với các hạt kim loại và không thể làm sạch được. Vì vậy cần phải có loại dầu mài phù hợp và thiết bị lọc hợp lý. Và thường xuyên, mạt kim loại trong thùng dầu chui ra để ngăn vi khuẩn xâm nhập vào dầu cắt gọt.
Lưu ý về tỷ lệ làm mát pha dầu. Tùy theo phương pháp gia công (tiện, phay, tarô, cắt gọt,...) mà bạn sẽ pha dầu với nước theo tỷ lệ nhất định do nhà sản xuất khuyến cáo.
- Khi pha dầu làm mát, luôn đổ dầu vào nước với thể tích xác định. Để dầu tan nhanh
- Không pha quá loãng nồng độ dung dịch làm mát, đo lại nồng độ sau khi pha bằng khúc xạ kế, hoặc đo nước và dầu theo đúng thể tích quy định của nhà sản xuất.
=> Ngoài ra để máy vận hàng tốt, ổn định thì khách hàng nên chọn loại dầu cắt gọt kim loại chất lượng, chính hãng. Vậy hãy tham khảo dầu cắt gọt kim loại bên công ty chúng tôi cung cấp nhé!
Địa điểm mua dầu cắt gọt kim loại uy tín, chất lượng
Công ty United Oil Việt nam là nhà phân phối dầu cắt gọt kim loại hàng đầu tại Miền Nam. Với hơn 20 năm kinh nghiệm trong lĩnh vực phân phối dầu nhớt và có kho hàng lớn nhất Miền Nam khách hàng cứ yên tâm về sản phẩm của chúng tôi được đảm bảo hàng CHÍNH HÃNG và GIÁ TỐT NHẤT cho quý khách hàng.
Ngoài việc cung cấp dầu cắt gọt kim loại, chúng tôi các loại dầu động cơ khác như: dầu động cơ, dầu tuần hoàn, dầu thủy lực, dầu máy nén khí (chuyên dùng trong máy bơm không khí công nghiệp). Mua hàng của công ty chúng tôi luôn đảm bảo quyền lợi của khách hàng lên hàng đầu. Qúy khách đang quan tâm tới dầu cắt gọt kim loại vui lòng liên hệ Hotline để được tư vấn rõ hơn.
Tham khảo: Các loại Dầu Cắt Gọt Kim Loại Pha Nước phổ biến nhất hiện nay
Các loại Dầu Cắt Gọt Kim Loại Không Pha Nước phổ biến nhất hiện nay
Nhà cung cấp dầu cắt gọt kim loại lớn nhất miền Nam
Bảng giá Dầu Cắt Gọt Kim Loại phổ biến nhất hiện nay
Cấu Tạo Máy Nén Khí 4 loại thông dụng nhất hiện nay
Máy nén khí Piston – Máy hơi là gì? Cấu tạo và nguyên lý hoạt động như thế nào?
Bảng giá dầu máy nén khí các hãng mới nhất năm 2023
Dầu máy nén khí chịu nhiệt độ cao
Tổng Hợp Các Lỗi Thường Gặp ở Máy Nén Khí Công Nghiệp
TOP 6 LOẠI DẦU MÁY NÉN KHÍ HIỆN NAY
CÁC LOẠI DẦU NHỚT TỐT NHẤT CHO MÁY NÉN KHÍ TRỤC VÍT VÀ PISTON
Nhớt thuỷ lực 68 là gì? Nhớt 68 loại nào tốt?
Top 7 loại dầu truyền nhiệt tốt nhất hiện nay
Bảng giá dầu truyền nhiệt Castrol, Shell, Caltex, Total, Mobil năm 2023
Kho dầu nhớt khổng lồ của công ty
Hotline:
Email: moboitronhq@gmail.com
Người gửi / điện thoại
CÁC BÀI MỚI HƠN
CÁC BÀI CŨ HƠN
CÔNG TY TNHH THƯƠNG MẠI DỊCH VỤ AN PHÚ ĐỨC
CÔNG TY TNHH UNITED OIL VIỆT NAM
Địa chỉ văn phòng: 109 Nguyễn Bá Tòng, Phường 11, Quận Tân Bình, TP HCM
Hotline: 0919770028
Kho hàng 1: 61/13 Đường Vĩnh Phú 41, Thuận An, TPHCM
Kho hàng 2: Thôn Nhơn Thọ 1, Xã Hòa Phước, Huyện Hòa Vang, TP Đà Nẵng.
Kho hàng 3: 82 Nguyễn Phúc Nguyên, Hương Long, TP Huế.
Kho hàng 4: 423 Minh Khai, Hai Bà Trưng, Hà Nội.
Kho hàng 5: Hẻm 1400, Nguyễn Ái Quốc, Khu phố 5, Phường Tân Phong, TP Biên Hòa, Đồng Nai
Kho hàng 6: 265 Mọ Kọ, Gung Ré, Di Linh, Lâm Đồng
Kho hàng 7: 40 Trần Anh Tông, Quy Nhơn, Gia Lai
Kho hàng 8: 47B, Hẻm 51, Đường 3/2, Phường Xuân Khánh, Quận Ninh Kiều, Thành phố Cần Thơ
Email: moboitronhq@gmail.com - MST 0313110360
Admin: Nguyễn Gia Quốc Bảo
Tuyển cộng tác viên kinh doanh dầu nhớt
Tham gia HIỆP HỘI DẦU NHỚT VÀ PHỤ TÙNG VIỆT NAM để tìm kiếm nguồn hàng và khách hàng dễ dàng hơn!
































